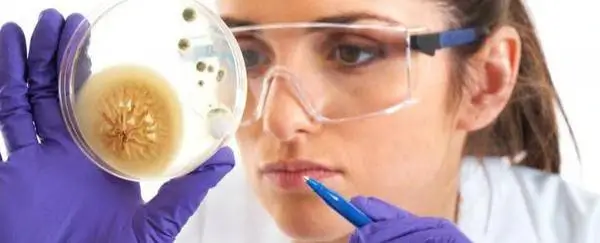

Про те, що спиртні напої шкідливі для здоров’я, відомо всім. Дехто звикає до них, навіть не замислюючись, наскільки страждають від етанолу внутрішні органи, а особливо головний фільтр організму – печінка. Не дивно, що охочим випити рано чи пізно доводиться дізнаватися, як відновити печінку після тривалого вживання алкоголю.

Існує три стадії захворювання печінки: жирова дистрофія, алкогольний гепатит і цироз. Ці хвороби призводять до погіршення самопочуття, а в результаті цирозу робота органу може припинитися, що загрожує летальним результатом. При відсутності своєчасного лікування здорові клітини покриваються рубцями, а запізніла терапія вже не приносить результатів.
Препарати – «реаніматори» печінки
Щоб відновити печінку в домашніх умовах медикаментозним шляхом, спочатку потрібно порадитися з лікарем. Прийом лікарських препаратів без призначення і зіставлення фахівцем інформації про властивості засобу та стан пацієнта, може обернутися катастрофою для організму. Якщо план лікування схвалений лікарем, його цілком можливо реалізувати вдома. Для очищення печінки, ураженої алкоголем, потрібні наступні ліки:
- відновлюючі з вмістом есенціальних фосфоліпідів: Есенціале, Есслівер;
- стимулюючі і регенеруючі, які включають вітамін В6 або В9, а також речовини, що сприяють появі нових клітин: Дипана, Силимар;
- препарати, які зберігають функції органуі підтримують клітини: Куперс Нео та інші;
- очисні (гепатопротектори), які знімають інтоксикації етанолом: комплекс зі споришем Гепа-Мерц, Леглан, при важких ураженнях – Корса, Гептралл.
Правильний підбір медикаментів для аптечки потерпілого від шкідливої звички та їх застосування згідно з інструкцією допоможуть як слід відновити печінку після тривалого вживання алкоголю, прискорити процес, який зазвичай займає декілька років.
Народні поради – поверне здоров’я

- лікуватися настоянкою розторопші – по ½ скл. щодня до прийому їжі;
- тричі на день пити чай з суміші ромашки, звіробою, безсмертника, мати-й-мачухи, споришу;
- збагатити меню артишоком;
- двічі на тиждень вживати по 1 л. фрешу з грейпфрута;
- їсти на сніданок нежирний подрібнений сир з цитрусовими, бананами або яблуками.
Прекрасною альтернативою таблеткам можуть бути відвари. Вони не затримуються в організмі надовго і не викликають залежності, тому вважаються найкращою рекомендацією для людей, які цікавляться народними засобами для відновлення печінки.
Настій з кульбаби і артишоку:
- 5 г. кореня кульбаби і таку ж кількість подрібненого артишоку залийте 1 скл. гарячої води;
- накрийте ємкість і настоюйте засіб 10 хвилин;
- пийте настій маленькими ковтками перед сном;
- курс лікування – від 1 до 1,5 місяця, в залежності від того, наскільки зруйнована печінка.
Відвар «Зелений порятунок»:
- змішайте сухий спориш, кропиву собачу, ягоди глоду і сушений кропив’яний лист в рівних частках;
- залийте все 250 мл. гарячої води, яка вже трохи покипіла;
- додайте в отриману рідину 1 ст. л. гречаного меду;
- приймайте відвар кожні 12 годин по 200 мл. до прийому їжі.
Настій «Відновлюючий»:
- 120 г. горобини і 80 г. щавлю залийте 1,5 л. окропу;
- пийте по 1 ст. л. тричі на добу за 40 хвилин до прийому їжі.
Цілющі зміни у способі життя
Лише відмовитися від руйнівних напоїв і приймати «зелені» або аптечні ліки задля швидкого й ефективного відновлення печінки в домашніх умовах, як це відбувається в спеціалізованому закладі, буде недостатньо. Адже на стан цього органу впливають всі звички людини.

- на декілька днів зменшити в меню кількість жирної і важкоперетравлюючої їжі;
- збільшити добовий об’єм води до 2-3 л;
- їсти багато фруктів;
- кожен день протягом 2 тижнів пити відвар шипшини до сніданку;
- раз в 3 доби перед сніданком, обідом або вечерею вживати 1 ст. л. оливкової олії або 2 перепелиних жовтки;
- уникати стресів і важких фізичних навантажень;
- займатися лікувальною фізкультурою.
Якщо хворий зловживає алкоголем уже тривалий час, то без більш тривалої спеціальної дієти йому не обійтися. Доведеться дотримуватися обмеження в їжі 2 місяці, але це не означає, що людину чекають муки голодом. Потрібно їсти 5-6 разів на день, віддаючи перевагу стравам з «правильних» корисних продуктів. У такому випадку включіть у меню:
- тушковані овочі: моркву, буряк, перець, помідори, часник, цибулю, ріпу, капусту, зелень;
- каші та перетерті супи з бобових, гороху, сочевиці, льону, рису;
- волоські горіхи і мигдаль;
- хліб з борошна грубого помелу;
- мед, патоку, халву;
- морську рибу;
- сирі рослинні олії.
Небажана їжа:
- молочна продукція;
- конина, яловичина, баранина, свинина, кролятина;
- яйця та вироби з борошна вищого сорту;
- цукор, варення, шоколад, солодощі, випічка;
- смажене насіння та арахіс.
Пристрасть до алкоголю – важкий удар по клітинах печінки. А найсумнішим є те, що життя без цього органу неможливе, а його відновлюючий ресурс з часом вичерпується. Якщо людина потрапила в тенета цієї шкідливої звички, обов’язково потрібно з них звільнитися. Але цього мало: важливо також переглянути свій спосіб життя, почати приймати традиційні чи народні ліки, щоб допомогти клітинам печінки відновитися. Врятуйте свій природний фільтр – він буде працювати для вас ще довгі роки!